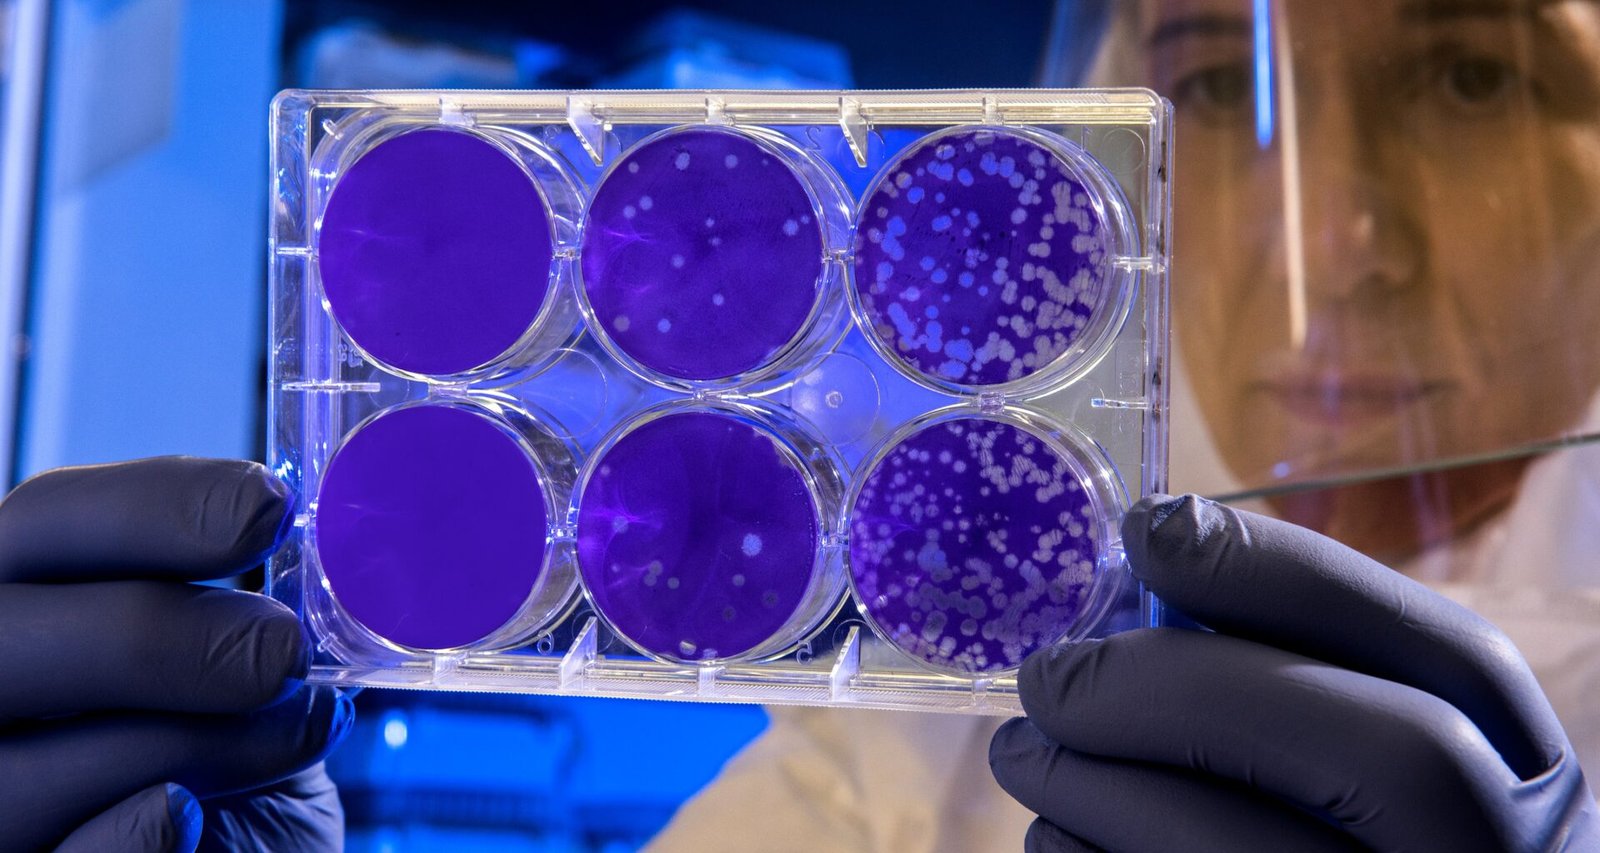

Эпидeмия началась 17 августа, и в настоящее время специалисты проводят тщательное расследование, направленное на выявление источника инфекции. Результаты анализов, полученные в понедельник, не помогли выявить источник заражения. В регионе проходит дезинфекция системы водоснабжения. Следующие результаты тестов будут готовы в течении 10 дней.
Учитывая стратегическое значение Жешува, в контексте национальной безопасности Польши, особое внимание уделяется исключению версии возможного саботажа. Так как Жешув является перевалочным пунктом для передвижения военной техники в Украину.
По последним данным, количество смертельных исходов от легионеллы достигло 14 человек. У 153 госпитализированных пациентов также была выявлена эта смертельная бактерия . По мнению мэра Жэшува, одним из главных факторов, который способствует распространению этой инфекции, является климат.
Легионелла вызывает легионеллез, который может закончиться пневмонией. Симптомы болезни легионеров: лихорадка, озноб, недомогание, анорексия, головные боли и миалгию, диарея (примерно в 50% случаев), а также сухой кашель, спутанность сознания, кровохарканье или брадикардия. Симптомы появляются в течение 2-10 дней после заражения.
Агентство внутренней безопасности (ABW) проводит расследование массового заражения легионеллой в Жешуве.